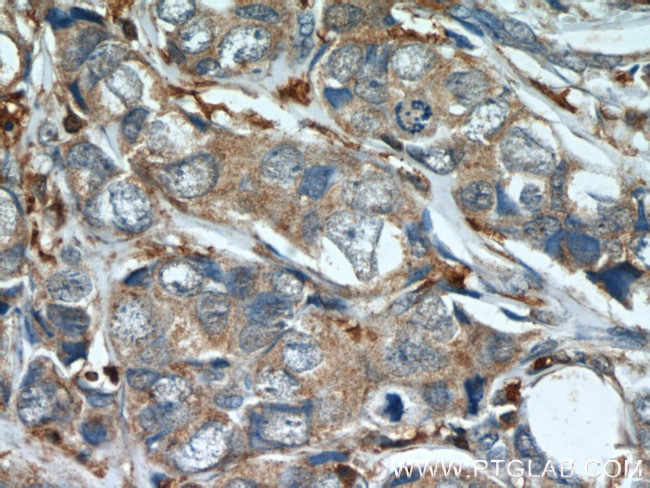
Mammaglobin A Antibody in Immunohistochemistry (Paraffin) (IHC (P))

Search
Proteintech
Mammaglobin A Polyclonal Antibody
{{$productOrderCtrl.translations['antibody.pdp.commerceCard.promotion.promotions']}}
{{$productOrderCtrl.translations['antibody.pdp.commerceCard.promotion.viewpromo']}}
{{$productOrderCtrl.translations['antibody.pdp.commerceCard.promotion.promocode']}}: {{promo.promoCode}} {{promo.promoTitle}} {{promo.promoDescription}}. {{$productOrderCtrl.translations['antibody.pdp.commerceCard.promotion.learnmore']}}
产品信息
23501-1-AP
种属反应
已发表种属
宿主/亚型
分类
类型
抗原
偶联物
形式
浓度
规格
纯化类型
保存液
内含物
保存条件
运输条件
产品详细信息
This polyclonal antibody is raised against the C-terminal 71 amino acids of the protein encoded by a cDNA.
Immunogen sequence: IDDNATTNA IDELKECFLN QTDETLSNVE VFMVISFSSY KLFKSPDQGQ VGSSFLTDNA KATSEQAFSY IG (50-120 aa encoded by BC067220)
靶标信息
Mammaglobin is a gene that is expressed almost exclusively in the normal breast epithelium and human breast cancer. It is a member of the secretoglobin gene family and forms a heterodimer with lipophilin B. It has been suggested that mammaglobin may be a useful marker for breast cancer clinical research. Studies investigating the detection of mRNA by RT PCR from circulating carcinoma cells in the peripheral blood of breast cancer patients have shown that mammaglobin is a highly specific marker and correlates with several prognostic factors, such as lymph node involvement.
仅用于科研。不用于诊断过程。未经明确授权不得转售。
生物信息学
蛋白别名: HGNC:7050; mammaglobin 1; mammaglobin A; Mammaglobin-1; Mammaglobin-A; MGC71974; prostatein; prostatic steroid binding protein 1; Secretoglobin family 2A member 2
基因别名: MGB1; PSBP1; SCGB2A2; UGB2
UniProt ID: (Human) Q13296
Entrez Gene ID: (Human) 4250